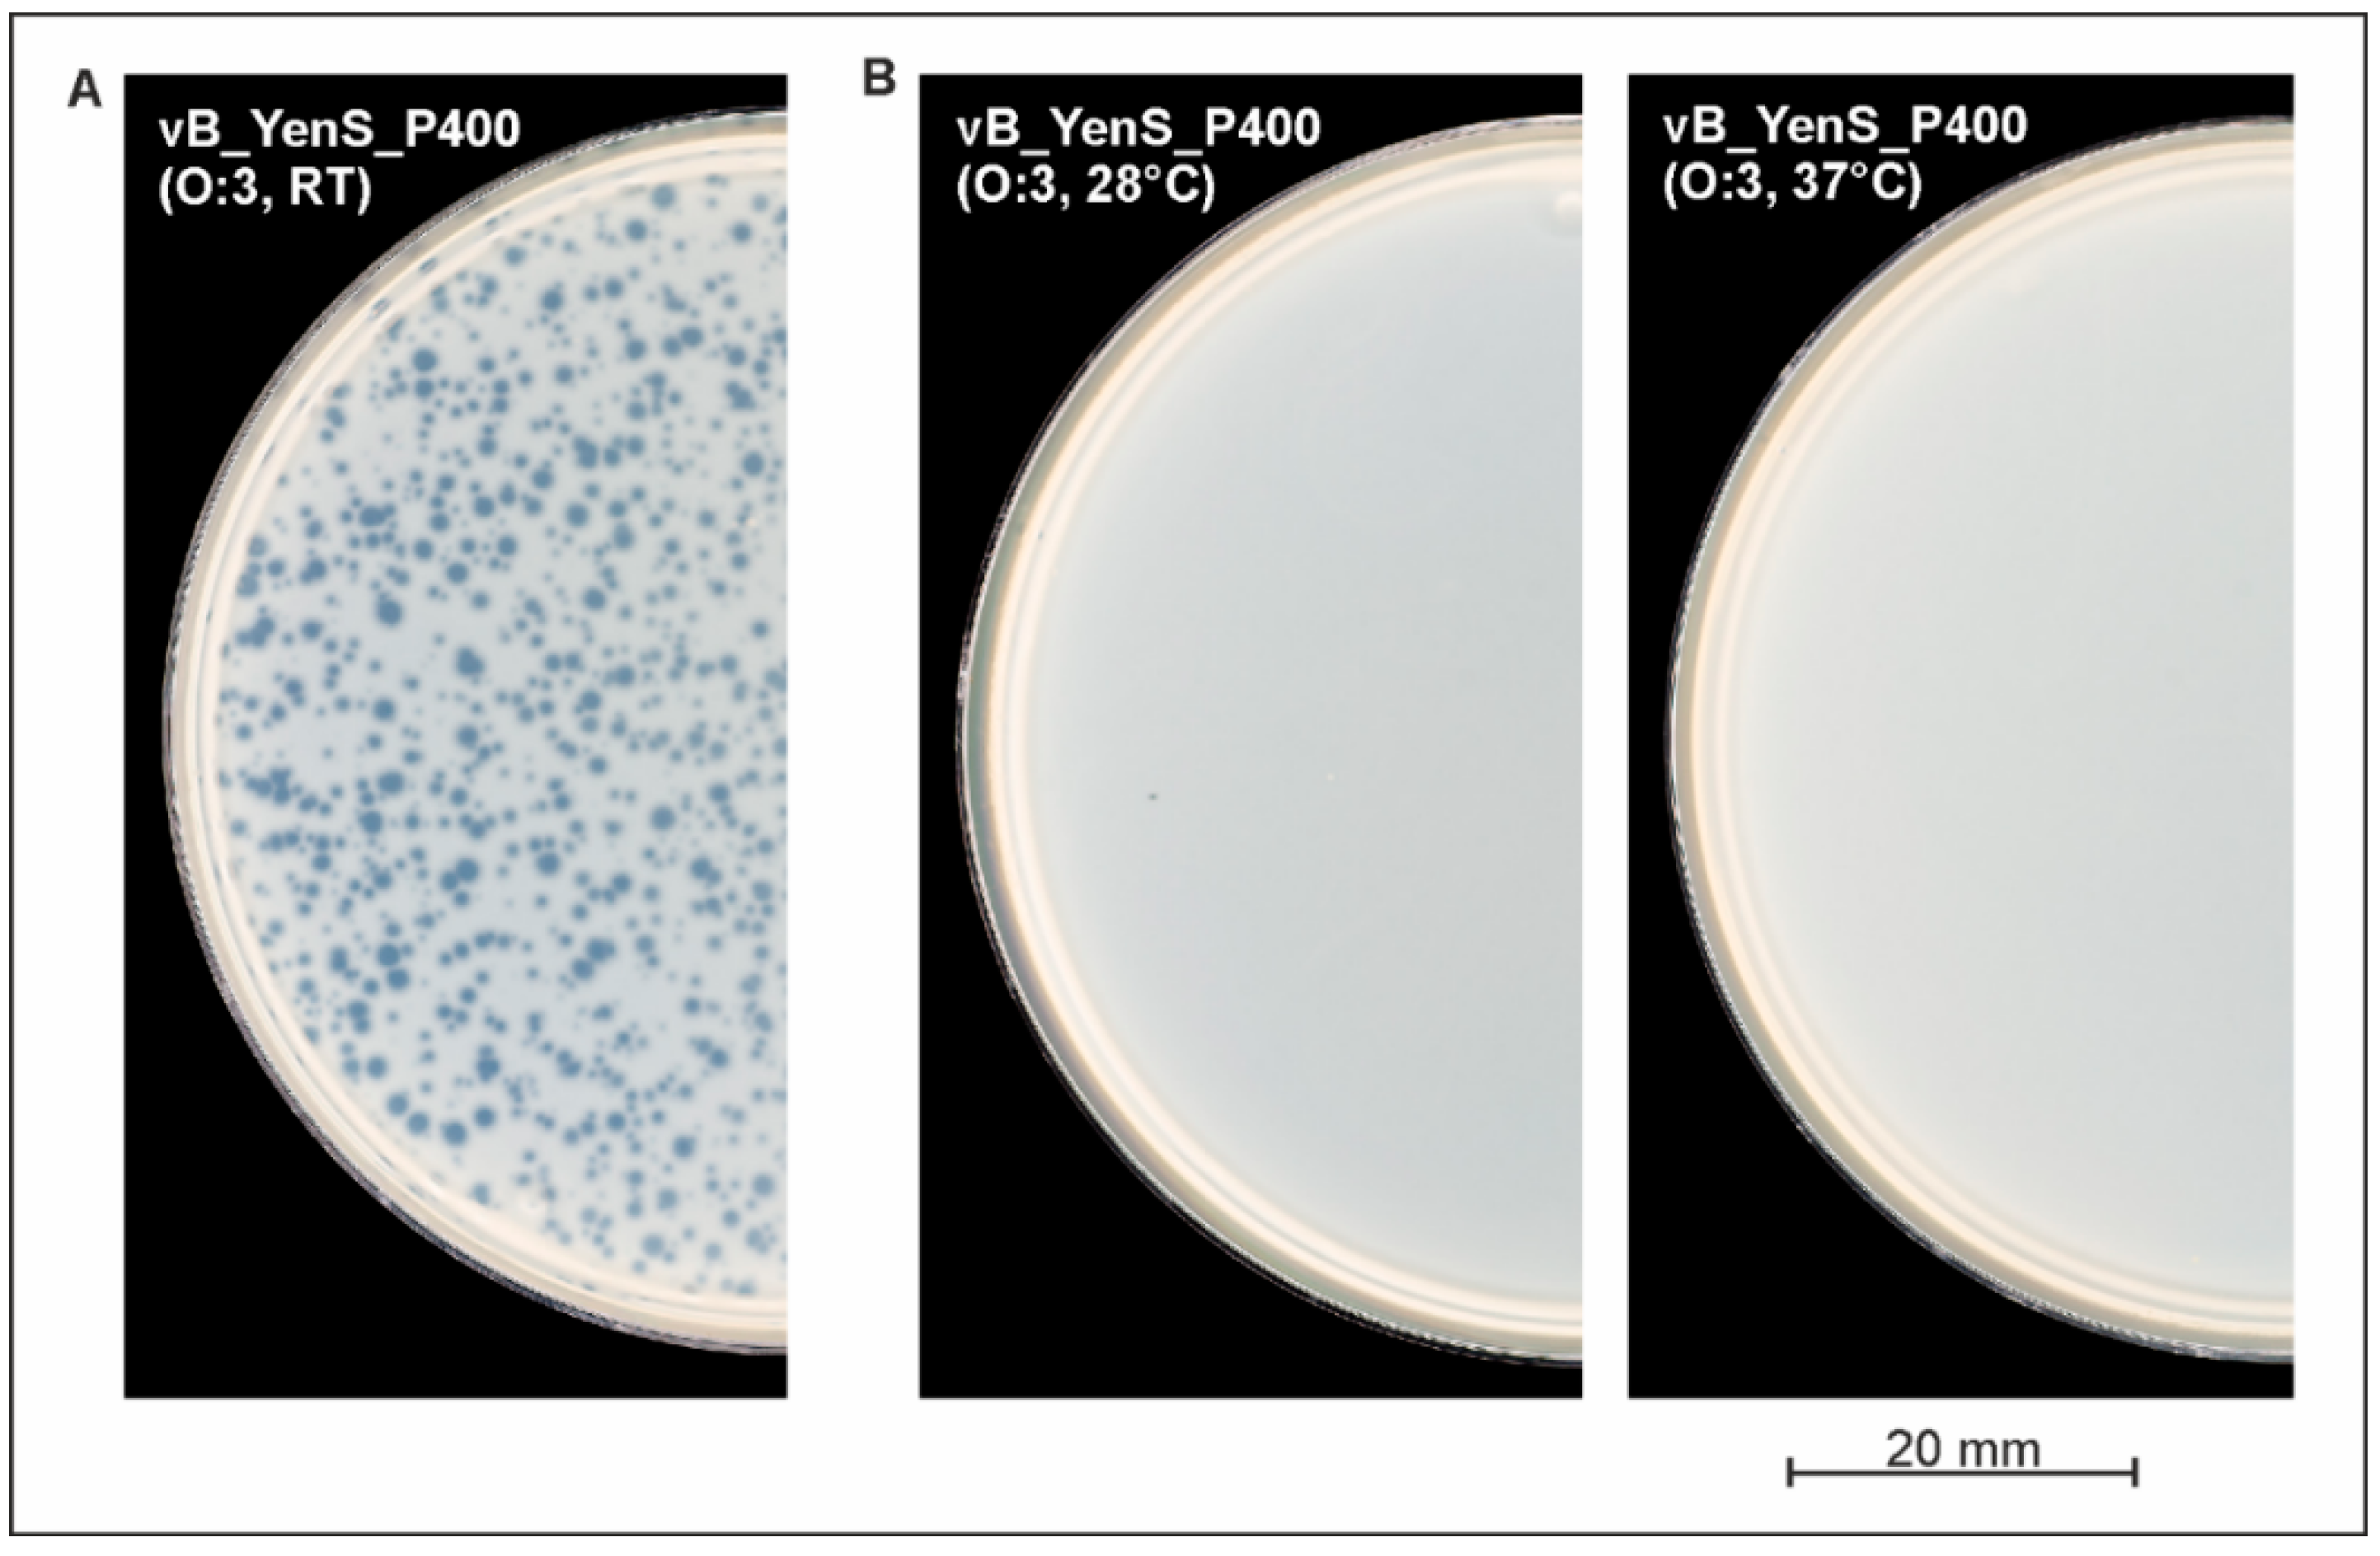
Microorganisms 10 01674 g002 Microorganisms 10 01674 g002

Phage vB_YenS_P400, a Novel Virulent Siphovirus of Yersinia enterocolitica Isolated from Deer
Abstract
1. Introduction
2. Materials and Methods
2.1. Bacterial Strains and Culture Conditions
2.2. Isolation, Propagation, and Purification of Phages
2.3. Host Range Determination
2.4. Lysogenization Experiment
2.5. Transmission Electron Microscopy (TEM)
2.6. Phage DNA Preparation, Sequencing, and Genome Analysis
2.7. Determination of the Page DNA End Structure
2.8. Nucleotide Sequence Accession
3. Results and Discussion
3.1. vB_YenS_P400 Is a Siphovirus Originating from Wildlife
3.2. vB_YenS_P400 Exhibited a Narrow Host Range
3.3. vB_YenS_P400 Is a Novel Virulent Siphovirus
3.4. The vB_YenS_P400 Genome Is Circularly Permutated
4. Conclusions
Author Contributions
Funding
Institutional Review Board Statement
Informed Consent Statement
Data Availability Statement
Acknowledgments
Conflicts of Interest
References
- European Food Safety Authority; European Centre for Disease Prevention and Control (ECDC). The European Union summary report on trends and sources of zoonoses, zoonotic agents and food-borne outbreaks in 2014. EFSA J. 2015, 13, 4329–4520. [Google Scholar] [CrossRef]
- Fredriksson-Ahomaa, M.; Stolle, A.; Korkeala, H. Molecular epidemiology of Yersinia enterocolitica infections. FEMS Immunol. Med. Microbiol. 2006, 47, 315–329. [Google Scholar] [CrossRef] [PubMed]
- Fredriksson-Ahomaa, M.; Stolle, A.; Siitonen, A.; Korkeala, H. Sporadic human Yersinia enterocolitica infections caused by bioserotype 4/O: 3 originate mainly from pigs. J. Med. Microbiol. 2006, 55, 747–749. [Google Scholar] [CrossRef] [PubMed]
- Laukkanen, R.; Martínez, P.O.; Siekkinen, K.-M.; Ranta, J.; Maijala, R.; Korkeala, H. Transmission of Yersinia pseudotuberculosis in the Pork Production Chain from Farm to Slaughterhouse. Appl. Environ. Microbiol. 2008, 74, 5444–5450. [Google Scholar] [CrossRef]
- Jamali, H.; Paydar, M.; Radmehr, B.; Ismail, S. Prevalence, characterization, and antimicrobial resistance of Yersinia species and Yersinia enterocolitica isolated from raw milk in farm bulk tanks. J. Dairy Sci. 2015, 98, 798–803. [Google Scholar] [CrossRef]
- MacDonald, E.; Einoder-Moreno, M.; Borgen, K.; Thorstensen Brandal, L.; Diab, L.; Fossli, O.; Guzman Herrador, B.; Hassan, A.A.; Johannessen, G.S.; Johansen, E.J.; et al. National outbreak of Yersinia enterocolitica infections in military and civilian populations associated with consumption of mixed salad, Norway, 2014. Euro Surveill. Bull. Eur. Sur Les Mal. Transm. = Eur. Commun. Dis. Bull. 2016, 21, 30321. [Google Scholar] [CrossRef]
- Terech-Majewska, E.; Pajdak, J.; Platt-Samoraj, A.; Szczerba-Turek, A.; Bancerz-Kisiel, A.; Grabowska, K. Characterization of Yersinia enterocolitica strains potentially virulent for humans and animals in river water. J. Appl. Microbiol. 2016, 121, 554–560. [Google Scholar] [CrossRef]
- Cilia, G.; Turchi, B.; Fratini, F.; Bilei, S.; Bossù, T.; De Marchis, M.L.; Cerri, D.; Pacini, M.I.; Bertelloni, F. Prevalence, Virulence and Antimicrobial Susceptibility of Salmonella spp., Yersinia enterocolitica and Listeria monocytogenes in European Wild Boar (Sus scrofa) Hunted in Tuscany (Central Italy). Pathogens 2021, 10, 93. [Google Scholar] [CrossRef]
- Syczyło, K.; Platt-Samoraj, A.; Bancerz-Kisiel, A.; Szczerba-Turek, A.; Pajdak-Czaus, J.; Łabuć, S.; Procajło, Z.; Socha, P.; Chuzhebayeva, G.; Szweda, W. The prevalence of Yersinia enterocolitica in game animals in Poland. PLoS ONE 2018, 13, e0195136. [Google Scholar] [CrossRef]
- Bancerz-Kisiel, A.; Pieczywek, M.; Łada, P.; Szweda, W. The Most Important Virulence Markers of Yersinia enterocolitica and Their Role during Infection. Genes 2018, 9, 235. [Google Scholar] [CrossRef]
- Joutsen, S.; Eklund, K.-M.; Laukkanen-Ninios, R.; Stephan, R.; Fredriksson-Ahomaa, M. Sheep carrying pathogenic Yersinia enterocolitica bioserotypes 2/O:9 and 5/O:3 in the feces at slaughter. Vet. Microbiol. 2016, 197, 78–82. [Google Scholar] [CrossRef] [PubMed][Green Version]
- Moorman, V.R.; Cohen, J.I. Insights into the individual evolutionary origins of Yersinia virulence factor effector proteins. Plasmid 2021, 114, 102562. [Google Scholar] [CrossRef] [PubMed]
- Leon-Velarde, C.G.; Kropinski, A.M.; Chen, S.; Abbasifar, A.; Griffiths, M.W.; Odumeru, J.A. Complete genome sequence of bacteriophage vB_YenP_AP5 which infects Yersinia enterocolitica of serotype O:3. Virol. J. 2014, 11, 188. [Google Scholar] [CrossRef] [PubMed]
- Liang, J.; Li, X.; Zha, T.; Chen, Y.; Hao, H.; Liu, C.; Duan, R.; Xiao, Y.; Su, M.; Wang, X.; et al. DTDP-rhamnosyl transferase RfbF, is a newfound receptor-related regulatory protein for phage phiYe-F10 specific for Yersinia enterocolitica serotype O:3. Sci. Rep. 2016, 6, 22905. [Google Scholar] [CrossRef] [PubMed]
- Pajunen, M.; Kiljunen, S.; Skurnik, M. Bacteriophage φYeO3-12, Specific for Yersinia enterocolitica Serotype O:3, Is Related to Coliphages T3 and T7. J. Bacteriol. 2000, 182, 5114–5120. [Google Scholar] [CrossRef]
- Hammerl, J.A.; Barac, A.; Erben, P.; Fuhrmann, J.; Gadicherla, A.; Kumsteller, F.; Lauckner, A.; Müller, F.; Hertwig, S. Properties of Two Broad Host Range Phages of Yersinia enterocolitica Isolated from Wild Animals. Int. J. Mol. Sci. 2021, 22, 11381. [Google Scholar] [CrossRef]
- Leon-Velarde, C.G.; Happonen, L.; Pajunen, M.; Leskinen, K.; Kropinski, A.M.; Mattinen, L.; Rajtor, M.; Zur, J.; Smith, D.; Chen, S.; et al. Yersinia enterocolitica-Specific Infection by Bacteriophages TG1 and ϕR1-RT Is Dependent on Temperature-Regulated Expression of the Phage Host Receptor OmpF. Appl. Environ. Microbiol. 2016, 82, 5340–5353. [Google Scholar] [CrossRef]
- Schwudke, D.; Ergin, A.; Michael, K.; Volkmar, S.; Appel, B.; Knabner, D.; Konietzny, A.; Strauch, E. Broad-Host-Range Yersinia Phage PY100: Genome Sequence, Proteome Analysis of Virions, and DNA Packaging Strategy. J. Bacteriol. 2008, 190, 332–342. [Google Scholar] [CrossRef]
- Happonen, L.J.; Pajunen, M.I.; Jun, J.W.; Skurnik, M. BtuB-Dependent Infection of the T5-like Yersinia Phage ϕR2-01. Viruses 2021, 13, 2171. [Google Scholar] [CrossRef]
- Hammerl, J.A.; Klein, I.; Lanka, E.; Appel, B.; Hertwig, S. Genetic and Functional Properties of the Self-Transmissible Yersinia enterocolitica Plasmid pYE854, Which Mobilizes the Virulence Plasmid pYV. J. Bacteriol. 2008, 190, 991–1010. [Google Scholar] [CrossRef]
- Jäckel, C.; Hammerl, J.A.; Reetz, J.; Kropinski, A.M.; Hertwig, S. Campylobacter group II phage CP21 is the prototype of a new subgroup revealing a distinct modular genome organization and host specificity. BMC Genom. 2015, 16, 629. [Google Scholar] [CrossRef] [PubMed]
- Jäckel, C.; Hertwig, S.; Scholz, H.C.; Nöckler, K.; Reetz, J.; Hammerl, J.A. Prevalence, Host Range, and Comparative Genomic Analysis of Temperate Ochrobactrum Phages. Front. Microbiol. 2017, 8, 1207. [Google Scholar] [CrossRef] [PubMed]
- Hammerl, J.A.; El-Mustapha, S.; Bölcke, M.; Trampert, H.; Barac, A.; Jäckel, C.; Gadicherla, A.K.; Hertwig, S. Host Range, Morphology and Sequence Analysis of Ten Temperate Phages Isolated from Pathogenic Yersinia enterocolitica Strains. Int. J. Mol. Sci. 2022, 23, 6779. [Google Scholar] [CrossRef]
- Hammerl, J.A.; Barac, A.; Bienert, A.; Demir, A.; Drüke, N.; Jäckel, C.; Matthies, N.; Jun, J.W.; Skurnik, M.; Ulrich, J.; et al. Birds Kept in the German Zoo “Tierpark Berlin” Are a Common Source for Polyvalent Yersinia pseudotuberculosis Phages. Front. Microbiol. 2022, 12, 634289. [Google Scholar] [CrossRef] [PubMed]
- Deneke, C.; Brendebach, H.; Uelze, L.; Borowiak, M.; Malorny, B.; Tausch, S. Species-Specific Quality Control, Assembly and Contamination Detection in Microbial Isolate Sequences with AQUAMIS. Genes 2021, 12, 644. [Google Scholar] [CrossRef] [PubMed]
- Hammerl, J.A.; Volkmar, S.; Jacob, D.; Klein, I.; Jäckel, C.; Hertwig, S. The Burkholderia thailandensis Phages ΦE058 and ΦE067 Represent Distinct Prototypes of a New Subgroup of Temperate Burkholderia Myoviruses. Front. Microbiol. 2020, 11, 1120. [Google Scholar] [CrossRef] [PubMed]
- Hertwig, S.; Klein, I.; Appel, B. Properties of the Temperate Yersinia enterocolitica Bacteriophage PY54. Adv. Exp. Med. Biol. 2003, 529, 241–243. [Google Scholar] [CrossRef]
- Hertwig, S.; Klein, I.; Lurz, R.; Lanka, E.; Appel, B. PY54, a linear plasmid prophage of Yersinia enterocolitica with covalently closed ends. Mol. Microbiol. 2003, 48, 989–1003. [Google Scholar] [CrossRef]
- Hertwig, S.; Klein, I.; Schmidt, V.; Beck, S.; Hammerl, J.A.; Appel, B. Sequence Analysis of the Genome of the Temperate Yersinia enterocolitica Phage PY54. J. Mol. Biol. 2003, 331, 605–622. [Google Scholar] [CrossRef]

| Time Point (min) | 0 | 60 | 65 | 70 | 75 | 80 | 85 | 90 | 95 | 100 | 105 | 110 | 115 | 120 | 180 |
|---|---|---|---|---|---|---|---|---|---|---|---|---|---|---|---|
| Test A (pfu) * | 16 | 13 | 12 | 14 | 13 | 18 | 21 | 49 | 96 | 155 | 199 | 238 | 264 | 368 | 900 |
| Test B (pfu) * | 13 | 17 | 15 | 11 | 23 | 21 | 33 | 58 | 104 | 149 | 205 | 228 | 242 | 340 | 900 |
| Mean (pfu) | 14.5 | 15 | 13.5 | 12.5 | 18 | 19.5 | 27 | 53.5 | 100 | 152 | 202 | 233 | 253 | 354 | 900 |
Publisher’s Note: MDPI stays neutral with regard to jurisdictional claims in published maps and institutional affiliations. |
© 2022 by the authors. Licensee MDPI, Basel, Switzerland. This article is an open access article distributed under the terms and conditions of the Creative Commons Attribution (CC BY) license (https://creativecommons.org/licenses/by/4.0/).
Share and Cite
Hammerl, J.A.; Barac, A.; Jäckel, C.; Fuhrmann, J.; Gadicherla, A.; Hertwig, S. Phage vB_YenS_P400, a Novel Virulent Siphovirus of Yersinia enterocolitica Isolated from Deer. Microorganisms 2022, 10, 1674. https://doi.org/10.3390/microorganisms10081674
Hammerl JA, Barac A, Jäckel C, Fuhrmann J, Gadicherla A, Hertwig S. Phage vB_YenS_P400, a Novel Virulent Siphovirus of Yersinia enterocolitica Isolated from Deer. Microorganisms. 2022; 10(8):1674. https://doi.org/10.3390/microorganisms10081674
Chicago/Turabian StyleHammerl, Jens A., Andrea Barac, Claudia Jäckel, Julius Fuhrmann, Ashish Gadicherla, and Stefan Hertwig. 2022. "Phage vB_YenS_P400, a Novel Virulent Siphovirus of Yersinia enterocolitica Isolated from Deer" Microorganisms 10, no. 8: 1674. https://doi.org/10.3390/microorganisms10081674
APA StyleHammerl, J. A., Barac, A., Jäckel, C., Fuhrmann, J., Gadicherla, A., & Hertwig, S. (2022). Phage vB_YenS_P400, a Novel Virulent Siphovirus of Yersinia enterocolitica Isolated from Deer. Microorganisms, 10(8), 1674. https://doi.org/10.3390/microorganisms10081674






